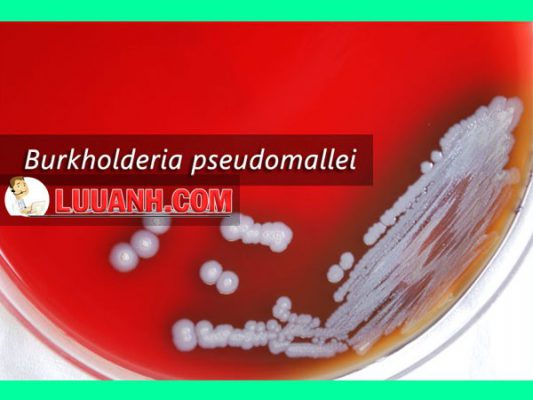

Những ngày gần đây, ở khắp nơi chúng ta đều thấy đưa tin về loại vi khuẩn “ăn thịt người” đáng sợ và căn bệnh Whitmore mà nó gây ra. Chỉ trong vòng tháng 8, Trung tâm Bệnh Nhiệt đới – Bệnh Viện Bạch Mai đã ghi nhân đến 12 trường hợp nhiễm loại vi khuẩn này. Vậy thì bệnh Whitmore là gì? Vi khuẩn Burkholderia pseudomallei gây ra bệnh Whitmore đáng sợ như thế nào và tại sao lại gọi nó là vi khuẩn “ăn thịt người”?
Bệnh Whitmore là gì?
Bệnh Whitmore (hay còn gọi là Meliodosis) là một bệnh nhiễm trùng cấp tính gây ra bởi vi khuẩn Burkholderia pseudomallei . Gần đây bệnh xuất hiện trở lại ở Việt Nam và đã có nhiều ca mắc mới được ghi nhận. Các dấu hiệu và triệu chứng của bệnh có thể từ sốt, đổi màu da, xuất hiện nhiều ổ áp xe đến viêm phổi, viêm não, viêm xương khớp, suy đa tạng và có thể dẫn đến tử vong. Bệnh Whitmore có thể bị chẩn đoán nhầm với các bệnh khác như Nhiễm khuẩn huyết do tụ cầu, Lao toàn thể khi chưa có các xét nghiệm vi sinh. Bệnh dễ xuất hiện trên các bệnh nhân có bệnh nền như đái tháo đường, tăng huyết áp và sau khi có vết thương hở tiếp xúc với bùn đất.

Vi khuẩn Burkholderia pseudomallei là gì?
Burkholderia pseudomallei là một vi khuẩn Gram âm, lưỡng cực, hiếu khí, hình que di động, thường sống trong đất ở các vùng nhiệt đới và cận nhiệt đới trên thế giới, là nguyên nhân gây ra bệnh Whitmore trên người và động vật.
B.pseudomallei có chiều dài từ 2 – 5 mcm và đường kính từ 0.4 – 0.8 mcm, có khả năng tự di chuyển bằng tiên mao. Vi khuẩn có thể phát triển trong các môi trường nhân tạo đặc biệt là các môi trường có chứa betaine và arginine, sinh ra cả nội độc tố và ngoại độc tố, vai trò của độc tố trong bệnh Whitmore chưa được xác định hoàn toàn.
Chẩn đoán vi khuẩn học: B. pseudomallei dễ phát triển trên nhiều môi trường (thạch máu, thạch MacConkey, EMB…), nuôi cấy thường có kết quả sau 24 – 48 giờ cho khuẩn lạc nhăn nheo, có màu kim loại và có mùi đất. Trên tiêu bản cho màu gram âm theo phương pháp nhuộm gram. Có thể chẩn đoán bằng phương pháp PCR tuy nhiên chưa được áp dụng trong lâm sàng.
Sức đề kháng: B. pseudomallei nhạy cảm với nhiều chất khử trùng thông thường : benzalkonium chloride, kali permanganat, iod, cồn 70o. Bị tiêu diệt bởi nhiệt độ cao 74oC trong 10 phút hoặc bằng tia UV. Khử trùng bằng clo không có hiệu quả tin cậy.
Khả năng gây bệnh: B. pseudomallei là một vi khuẩn gây bệnh cơ hội, thường xâm nhập vào cơ thể qua các vết thương hở khi tiếp xúc với bùn đất, có khả năng trùng hợp actin từ tế bào này qua tế bào khác và tiết ra các độc tố nguy hiểm. Tỷ lệ tử vong do bệnh Whitmore là từ 20 – 50% cho dù có điều trị, tỷ lệ tử vong cao có thể do bệnh được chẩn đoán muộn dẫn đến giai đoạn nặng, xuất hiện các biến chứng như sốc nhiễm khuẩn, suy đa tạng

Vắc xin phòng bệnh
Hiện chưa có vắc xin đặc hiệu phòng bệnh, nếu xảy ra các dấu hiệu nghi nhiễm B. pseudomallei cần đến các cơ sở y tế ngay để được chẩn đoán và điều trị.
Triệu chứng của bệnh Whitmore
Triệu chứng của bệnh Whitmore thường khác nhau tuỳ thuộc vào loại nhiễm trùng, các loại Whitmore bao gồm phổi, máu, nhiễm khuẩn tại chỗ và lan truyền.
– Các vết loét thường gặp ở gan, phổi, lách và tuyến tiền liệt, ít xuất hiện trên xương, khớp, hạch bạch huyết và não.
– Nhiễm trùng phổi: Dấu hiệu phổ biến nhất của Whitmore là nhiễm trùng phổi, có thể xảy ra đầu tiên hoặc là hậu quả của nhiễm khuẩn huyết, từ nhẹ như viêm phế quản hoặc nặng hơn là viêm phổi và có thể dẫn đến sốc nhiễm khuẩn. Các triệu chứng của nhiễm trùng phổi có thể bao gồm:
- Ho: ho khan hoặc ho có đờm
- Sốt cao
- Đau ngực khi thở
- Đau đầu và đau nhức cơ
- Giảm cân
Nhiễm B.pseudomallei phổi có thể bị nhầm với lao, kể cả khi đã có hình ảnh X-quang phổi.

– Nhiễm khuẩn huyết: Nếu không được điều trị nhanh chóng, bệnh có thể diễn biến thành nhiễm khuẩn huyết, có thể xảy ra các biến chứng như sốc nhiễm khuẩn, suy đa tạng với tỷ lệ tử vong cao, các triệu chứng thường bao gồm:
- Sốt, kèm theo rét run và đổ mồ hôi
- Đau đầu; đau khớp và đau cơ
- Đau họng
- Mất phương hướng
- Khó thở
- Tiêu chảy
- Đau bụng trên
- Vết loét có mủ trên da hoặc bên trong
Nguy cơ xảy ra nhiễm khuẩn huyết tăng lên trên các bệnh nhân có các bệnh nền như: đái tháo đường; bệnh gan, thận mạn tính, thalassemia, bệnh phổi tắc nghẽn mạn tính, ung thư hoặc các tình trạng suy giảm miễn dịch. Người bệnh trên 40 tuổi cũng có nguy cơ bị nhiễm khuẩn huyết cao hơn người trẻ tuổi.
– Nhiễm khuẩn tại chỗ: Ảnh hưởng tới da và các cơ quan ngay dưới da, nhiễm khuẩn tại chỗ có thể lan đến máu, các triệu chứng có thể bao gồm:
- Đau hoặc sưng ở một khu vực chứa (cục bộ) chẳng hạn như tai và tuyến mang tai, thường liên quan nhất đến quai bị và dễ bị chẩn đoán nhầm.
- Sốt
- Loét hoặc áp xe trên, hoặc ngay bên dưới da – chúng có thể bắt đầu như những nốt sần, màu xám hoặc trắng, sau đó trở nên mềm và viêm, trông giống vết thương.
– Nhiễm khuẩn lan truyền: Trong loại Whitmore này, vết loét hình thành ở nhiều cơ quan và có hoặc không liên quan đến sốc nhiễm khuẩn, các triệu chứng có thể bao gồm:
- Sốt, đau đầu, co giặt
- Giảm cân, sụt cân
- Đau dạ dày hoặc ngực
- Đau cơ hoặc khớp
Chẩn đoán
Whitmore có thể ảnh hưởng đến nhiều cơ quan và dễ chẩn đoán nhầm với nhiều bệnh khác, do đó tỷ lệ tử vong của bệnh thường cao do chẩn đoán muộn.
Tiêu chuẩn vàng trong chẩn đoán Whitmore chính là nuôi cấy phân lập vi khuẩn B. pseudomallei từ bệnh phẩm như máu, đờm, mủ, nước tiểu, dịch bao hoạt dịch, dịch màng bụng, dịch màng tim… Môi trường nuôi cấy có thể là thạch máu, thạch Macconkey, EMB… Tuy nhiên kết quả nuôi cấy âm tinh cũng không cho phép bỏ qua trường hợp mắc Whitmore.
Điều trị
– Điều trị kháng sinh là bắt buộc tuỳ thuộc vào các loại Whitmore
– Giai đoạn đầu điều trị bệnh Whitmore là tối thiểu 10 – 14 ngày điều trị kháng sinh bằng tĩnh mạch (IV) và thời gian điều trị có thể kéo dài đến 8 tuần. Có thể lựa chọn một trong hai:
- Ceftazidime 2g (Fortaz, Tazicef) (50 mg/kg đối với trẻ em, tối đa 2g) tiêm tĩnh mạch mỗi 6 giờ ít nhất 14 ngày
- Meropenem 1g (Merrem, Meronem) (25 mg/kg đối với trẻ em, tối đa 1g) tiêm tĩnh mạch mỗi 8 giờ ít nhất 14 ngày.
– Giai đoạn thứ hai kéo dài từ 3 – 6 tháng với kháng sinh đường uống:
- Co – trimoxazol (Sulfamethoxazol + Trimethoprim) (Bactrim, Biseptol) uống mỗi 12 giờ
- Doxycyclin (Alodox, Cyclindox) uống mỗi 12 giờ.
Tái phát hầu như không xảy ra, chỉ xuất hiện trên các trường hợp không tuân thủ điều trị bằng kháng sinh.
Dịch và tổng hợp: Quang Sáng
Nguồn tham khảo:
https://www.healthline.com/health/melioidosis
https://vi.wikipedia.org/wiki/Burkholderia_pseudomallei
https://www.ncbi.nlm.nih.gov/pubmed/10093229
https://jcm.asm.org/content/54/12/2866
Copy ghi nguồn: https://www.vnras.com/drug/